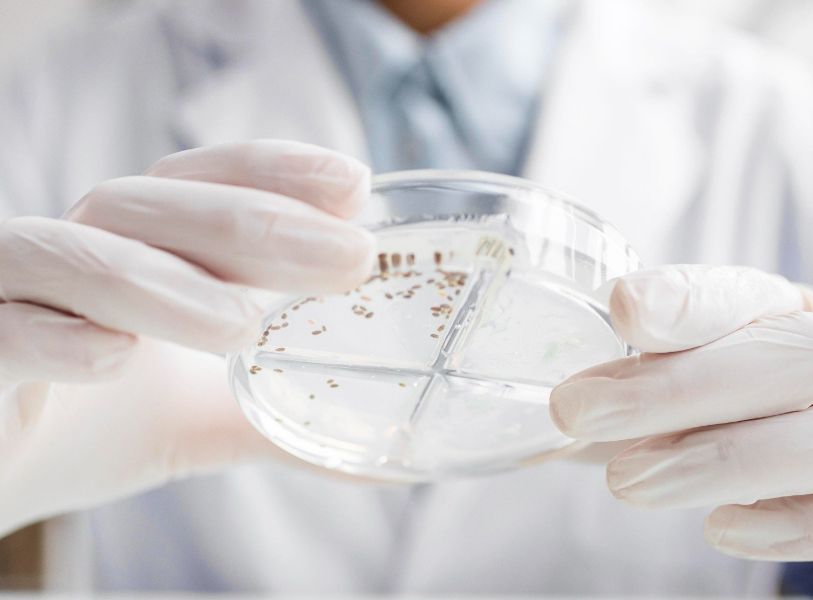

Products and Services
Our Products
Rapid and accurate kits for medical, agricultural, and forensic diagnostics.
High-quality lab tools for research and diagnostics.
Essential consumables like pipette tips, tubes, and more.
Key chemicals for DNA extraction, PCR, and microbiology.
Hands-on kits to inspire young scientists and engineers.
Testing Services
Metagenomics

Water Quality Testing

Soil Pathogen Detection

Microscopy-Based Screening Assays
We analyze genetic material from environmental samples to study microbes, helping with pathogen identification and environmental health.
We test water for contaminants and pathogens, ensuring safe drinking water and supporting agriculture and industry.
We detect harmful microorganisms in soil, helping prevent crop diseases and supporting sustainable farming.
We use high-resolution imaging to analyze cells and microbes, aiding in diagnostics, drug development, and agricultural research.
Partners




